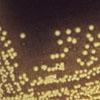

Cholera is an acute diarrheal illness caused by infection of the intestine with the bacterium Vibrio cholerae. The infection is often mild or without symptoms, but can sometimes be severe. In severe cases, rapid loss of body fluids leads to dehydration and shock. Without treatment, death can occur within hours.
Additional ResourcesFor more information contact:
- Your local health office, or call our Health Info Hotline at 1-866-HLTHY4U (1-866-458-4948)